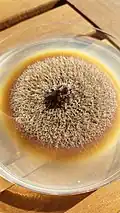
Endomicoriză Cairneyella variabilis

Mycorrhiza

Micoriza (în plural: micorize), cu numele științific Mykorrhiza, este o formă de simbioză între fungi și plante în care o ciupercă intră în contact cu sistemul rădăcinilor fine unei plante. Denumirea este derivată din cuvintele (gr. μύκης=ciupercă) și (gr. ῥίζα=rădăcină).[1]
Istoric


Endosimbiontul (orice organism care trăiește în beneficiul reciproc în corpul sau celulele unui alt organism) originar, probabil un Glomeromycetes, a apărut cu aproximativ 450 de milioane de ani în urmă în Paleozoic, probabil în același timp cu primele plante terestre.
Sedimentul paleontologic din Devonian în care au fost descoperite fosile prinse în silicolit (denumit Rhynie Chert), de exemplu Aglaophyton, cu o vârstă de aproximativ 400 de milioane de ani, arată componente morfologic identice cu specii din ordinul Glomales. Acest fapt sugerează că micorizele au fost instrumentul de colonizare accelerată a terenurilor emergente prin capacitatea lor de a extrage apă și minerale din sol.[2] Aceste asociații timpurii au fost, de asemenea, capabile să creeze un sol mai rezistent la intemperii, să păstreze mai bine apa, îmbunătățind în același timp rezistența plantelor privind stresul osmotic și în timp răcoros (mai puțin de 15° C), în plus probabil contribuția la o mai bună supraviețuire a ciupercii în solurile înghețate de iarnă, în care micro-ciupercile suferă sub un factor de selecție suplimentar (De aceste „simbioze reci” beneficiază, de asemenea, ierburi, cum ar fi orzul.)[3] sau lipsa azotului (de exemplu la molizi), mai departe rezistența lor cu privire la vânt și scurgere și, probabil, rezistența lor la intensitățile excesive ale luminii.[4]
Legătura de ciuperci cu rădăcini de plante au fost cunoscute cel puțin de la mijlocul secolului al XIX-lea. Dar descoperirea micorizei a fost un proces în mai multe etape. Astfel, observatorii timpurii au înregistrat doar pur și simplu acest fapt fără a a cerceta în amănunțime relațiile dintre cele două organisme. În anii 1840-1880 au apărut diverse observații individuale, care au avut legătură cu fenomenul. Dar de abia botanistul de cetățenie prusac, dar origine polonă, Franz Michailow von Kamienski (1851-1912) a studiat și descris fenomenul din 1879 și rezultatele le-a publicat în 1882.[5].
Cercetări suplimentare au fost efectuate de botanistul și micologul german Albert Bernhard Frank (1839-1900), care a introdus termenul Mycorrhiza în 1885. Cei doi savanți au recunoscut imaginea generală corect și au publicat lucrări cu experimente fundate în mod clar.[6]
Datorită capacității lor de a livra substanțe nutritive direct la rădăcinile culturilor, în prezent se investighează dacă ciupercile pot fi folosite ca înlocuitori ai îngrășămintelor minerale. Raza de acțiune statistică pentru stocurile de îngrășăminte anorganice, în special privind fosforul, este de numai 50 până la 100 de ani (fosfor de vârf). [4] Micoriza poate fi o alternativă.[7]
Definiție și descriere
Micorizele sunt o componentă majoră a edafonelor (totalitatea organismelor care trăiesc în sol, inclus microorganismele).[8] În această legătură, hifele unei ciuperci, fiind organul principal al ei, colonizează rădăcinile unei plante. Ceea ce se numește în mod obișnuit ciupercă, adică piciorul și pălăria, este doar un organ efemer al ciupercilor, sporiferul, unde are loc reproducerea sexuală. Ele sunt ca niște filamente fine, capabile să exploreze un volum foarte mare de sol (mii de metri de filamente miceliene pentru un metru de rădăcină). Astfel, ciupercile furnizează substanțe nutritive și apă pentru plante, iar la rândul lor primesc o parte din asimilatele produse prin fotosinteza plantelor verzi. Astfel, într-o pădure de foioase de exemplu, aproximativ o treime din produsele fotosintetice sunt consumate de ciupercile micorize. Spre deosebire de alte ciuperci de sol, multe din aceste soiuri au lipsă a enzimelor necesare pentru descompunerea carbohidraților complecși. De aceea depind de producția plantei. Deși relația micoriză este de tip simbiotic, un dezechilibru în relație care poate fi cauzat de o slăbiciune a unuia dintre cei doi parteneri, asocierea poate să schimbe în mod neintenționat de-a lungul continuului mutual-parazit. Ciuperca poate ajuta, de asemenea, să recicleze masa pierită în favoarea celor doi descendenți ai săi.[9][10]
Clasificare
Datorită caracteristicilor specifice, micorizele sunt împărțite în mod tradițional în trei grupuri diferite: ectomicorize, endomicorize și micorize arbusculare. O altă clasificare face distincția între cinci micorize, anume ortoide, ectopice, arbutoide, ericoide și arbusculare precum două forme antagoniste (orhidee și monotropoide).[11]
Ectomicoriză
Miceliul (toate hifele ramificate) formează o teacă densă în jurul vârfurilor rădăcinoase tinere, încă fără scoarță. Ca reacție, capetele rădăcinilor se umflă și nu mai dezvoltă fire păroase. După ce acele lipsesc, hifele ciupercii preiau responsabilitatea. Astfel, hifele fungide cresc în cortexul rădăcinii, dar nu penetrează în celulele lor, ci formează în spațiile extracelulare o rețea care facilitează schimbul de nutrienți între ciupercă și plantă, așa numita „Rețeaua Hartwig” (după botanistul silvicultor german Robert Hartig, 1839-1901). Ele ajung foarte departe în matricea solului, asigurând o absorbție bună și extinsă a nutrienților și a apei. În plus, micorizele protejează rădăcina copacilor de infecții prin penetrarea de bacterii sau altor ciuperci.
În timp ce majoritatea partenerilor de plante pot să se dezvolte bine și fără ciuperci în locuri potrivite, există unii dintre ei, care sunt obligați să aibă bureții ca partener. Forma de ectomicoriză este tipică în legătură cu mesteacăn, fag, pin, salcie și trandafir. Partenerii din Regnul Fungi sunt, de obicei, ciuperci din ordinele Boletales și Agaricales din încrengătura Basidiomycota, în cazuri rare, de asemenea, câteva specii din cea de Ascomycota, cum au fi trufele sau soiuri din ordinul Pezizales. Se presupune că multe ciuperci mari, în Europa peste 1.000 de specii, dintre altele cele care aparțin genurilor Amanita, Cantharellus, Clitopilus, Chroogomphus, Cortinarius, Gomphidius, Gyromitra (parțial), Hebeloma, Hygrophorus, Hydnum, Inocybe, Laccaria, Lactarius, Leccinum, Paxillus, Phylloporus, Ramaria (parțial), Russula, Suillus, Tricholoma, Tylopilus, Xerocomellus sau Xerocomus, sunt capabile de acest fel de simbioză.[12][13] În urmare o galerie (tip de gen) ale acestor genuri:
 Amanita muscaria
Amanita muscaria Cantharellus cibarius
Cantharellus cibarius Clitopilus prunulus
Clitopilus prunulus Chroogromphus rutilus
Chroogromphus rutilus- Cortinarius violaceus
.jpg) Gomphidius glutinosus
Gomphidius glutinosus Gyromitra esculenta
Gyromitra esculenta Hebeloma crustuliniforme
Hebeloma crustuliniforme
 Hygrophorus eburneus
Hygrophorus eburneus Hydnum repandum
Hydnum repandum Inocybe relicina
Inocybe relicina Laccaria laccata
Laccaria laccata.jpg) Lactarius torminosus
Lactarius torminosus- Leccinum aurantiacum
 Paxillus involutus
Paxillus involutus Phylloporus pelletieri
Phylloporus pelletieri
.jpg) Ramaria botrytis
Ramaria botrytis Russula emetica
Russula emetica- Suillus luteus
- Tricholoma equestre
 Tylopilus felleus
Tylopilus felleus Xerocomus chrysenteron
Xerocomus chrysenteron Xerocomus subtomentosus
Xerocomus subtomentosus
Endomicoriză
Aici o parte din hifele ciupercii pătrunde în celulele scoarței rădăcinii partenerului de plante. Acestea din urmă sunt predominant plante erbacee, numai în cazuri rare copaci. Rețeaua de hife care înconjoară rădăcina la ektomicoriză lipsește aici. În interiorul celulei, ciupercile formează un fel de organ de aspirație pentru absorbția nutrienților (haustorium). Astfel, eliberarea substanțelor nutritive și a apei precum absorbția carbohidraților devine posibilă. Speciile de plante din următoarele familii sunt aproape întotdeauna în simbioză cu un partener de ciuperci: Ericaceae, Monotropoideae și Orchidaceae. Ciupercile simbiotice sunt, în cea mai mare parte, Basidiomycota|basidiomicete]] din ordinul Cantharellales, precum și formele lor anamorfice Rhizoctonia și Ceratorhiza. Cel puțin pentru orhidee, această formă de endomicoriză este obligatorie pentru dezvoltarea lor.[12][13][14]
Micorize arbusculare
Micoriza arbusculară, în lucrări științifice mai vechi de asemenea numită „micoriză sau vezicular-arbusculară”, este o formă specială de endomicoriză. Tipic pentru acest fel cel mai frecvent de micoriză sunt formarea de arbusculi, acestea sunt hife ramificate, fine și fragede în formă de copăcel în interiorul celulelor rădăcinii care conțin rezerve. Ele se reproduc doar asexual. Cu toate acestea, hifele diferiților indivizi se pot îmbina, ceea ce face posibil un schimb genetic și o formă de parasexualitate. Ele sunt și unice din punct de vedere genetic, deoarece sporii lor au mai multe nuclee genetic diferite.[15] Unele specii formează de asemenea vezicule (în țesutul rădăcinii plantei se formează celule fungide cu pereți groși). Numărul de plante care pot beneficia de micoriza arbusculară este foarte mare. Printre acestea se numără multe culturi a căror aprovizionare crescută cu fosfat, datorită simbiozei, poate avea un efect pozitiv asupra randamentului. Ciupercile implicate sunt alocate soiurilor de fungi arbusculari micorizali în încrengătura nou creată Glomeromycota. Toți acești bureți au pierdut reproducerea sexuală.[12][13][16] Mai există două subcategorii:[14]
- Endomicorize ericoide: Hifele formează aici pelicule în rădăcini tranzitorii cu diametru mic. Implicate sunt numai ascomicete sau basidiomicete în simbioză cu ordinul Ericales.
- Ectendo-micorize: Ciuperca formează plutoni intracelulari și un strat în jurul rădăcinii. Acesta este cazul în legătură cu Ericales. Ectendo-micorizele monotropoide se găsesc și în Ericales non-clorofile. Hifele formează pelicule în celulele superficiale ale rădăcinii.
Ektomicoriza și Endomicoriza (imagini)
 Valorificarea în dependența soiului de ciuperci
Valorificarea în dependența soiului de ciuperci Ektomicoriză Amanita muscaria
Ektomicoriză Amanita muscaria Endomicoriză Cairneyella variabilis
Endomicoriză Cairneyella variabilis
Importanța pentru aprovizionarea cu fosfați
Dintre cele trei elemente nutritive anorganice principale de plante este adesea factorul limitativ în special fosfatul deoarece nu este disponibil ca potasiul, rezolvat în întregime liber și, de asemenea, nu absorbind în mod activ ca nitratul, ci doar pasiv prin difuziune. Prin urmare, pentru a putea să se aprovizioneze în mod eficient cu fosfat, rădăcina plantei ar trebui să pătrundă din ce în ce mai departe în zone neexplorate ale solului, dacă nu ar exista ciuperci micorize care în majoritatea cazurilor preiau această treabă. Firește, în solurile humoase, cum au fi cele forestiere, cea mai mare parte a fosfatului este legat organic sub formă de fosfat inozitol (acid fitic [?]).Aici se ivește calitatea deosebită a ciupercilor ectomicoriziale de a elibera astfel fosfații de compușii organici. Copacii din pădure formează împletituri de rădăcini pentru micoriză direct sub frunzele de pe pământ, acoperind în acest mod cea mai mare parte a nevoilor lor de fosfat.[6]
Importanța ecologică generală
Importanța micorizei pentru ecologie nu se limitează doar la absorbția apei și a nutrienților din sol. Plantele simbiotice sunt adesea mai competitive și mai tolerante față de stresul mediului decât cele fără micoriză. Alte avantaje sunt (în rând alfabetic):[17][18]
- absorbția de substanțe nutritive prezente în forme care nu sunt disponibile în mod normal pentru plante, de exemplu azot în compuși organici,
- acumularea de nutrienți,
- beneficii non-nutriționale datorită, de exemplu, producției de fitohormoni,
- capacitatea de a neutraliza compuși fenolici și metale toxice prezente în sol,
- crearea de rețele nutriționale,
- influență asupra populațiilor microbiene ale rizosferei, prin schimbări calitative și cantitative ale exsudațiilor rădăcinii,
- influență importantă asupra structurii solului, care este îmbunătățit,
- influență pe cicluri nutritive la nivel de ecosistem,
- influență pe secvențele primare și secundare ale speciilor de plante la nivel de ecosistem,
- protecție împotriva ciupercilor și nematodelor parazitare,
- protecție împotriva stresului cauzat lipsei de apă,
- sprijin pentru răsaduri furnizate pus la dispoziție de rețelele hifelor în sol,
- transferul de nutrienți de la plante moarte la plante vii.
Note
- ↑ Wilhelm Gemoll: „Griechisch-Deutsches Schul- und Handwörterbuch” Editura F. temsky, Viena sia G Freytag, Leipzig, 1908, p. 512
- ↑ [T.N. Taylor: „Perithecial ascomycetes from the 400 million year old Rhynie chert: an example of ancestral polymorphism”, în: „ Mycologia”, vol. 97, nr. 1, 2005, p. 269-285
- ↑ Mark Tibbett, John W.G. Cairney: „The cooler side of mycorrhizas: their occurrence and functioning at low temperatures”, în: „Revue canadienne de botanique”, Editura NRC Research Press, vol.85, nr. 1, Ottawa 2007, p. 51-62
- ↑ I. J. Alexander, R. I. Fairley: „ Effects of N-fertilization on populations of fine roots and mycorrhizas in spruce humus”, în jurnalul „Plant and Soil”, vol. 71, Editura Springer, New York 1983, p. 49-53
- ↑ F. Kamienski: „Les organes végétatifs de Monotropa hypopitys L.”., în: „Mémoires de la Societé Nationale des Sciences Naturelles et Mathématiques de Cherbourg”, seria 3, vol. 24, Cherbourg 1882, p. 5-40
- 1 2 David H. Jennings, Gernot Lysek: „Fungal Biology: Understanding the Fungal Lifestyle”, Editura BIOS Scientific Publishers, Oxford 1996, p. 57-58
- ↑ Confederația Elvețiană
- ↑ „Forstcast”. Arhivat din original la . Accesat în .
- ↑ Margaret L. Ronsheim: „The Effect of Mycorrhizae on Plant Growth and Reproduction Varies with Soil Phosphorus and Developmental Stage”, Editura University of Notre Dame „The American Midland Naturalist”, în: „The American Midland Naturalist”, vol. 167, nr.1, Indiana 2012, p. 28-39
- ↑ Marcel Bon: „Pareys Buch der Pilze”, Editura Kosmos, Halberstadt 2012, p. 7, ISBN 978-3-440-13447-4
- ↑ Sally E. Smith, David J. Read: „Mycorrhizal Symbiosis”, Editura Academic Press, 1997, ISBN 0-12-652840-3, p. 605
- 1 2 3 Bruno Cetto: „Der große Pilzführer”, vol. 1, ed. a 5-a, Editura BLV Verlagsgesellschaft, München, Berna, Viena 1979, p. 14-22, ISBN 3-405-12116-7
- 1 2 3 Linus Zeitlmayr: „Knaurs Pilzbuch”, Editura Droemer Knaur, München-Zürich 1976, p. 18-22, ISBN 3-426-00312-0
- 1 2 Johannes C. G. Ottow: „Mikrobiologie von Böden: Biodiversität, Ökophysiologie und Metagenomik”, Editura Springer, Berlin – Heidelberg 2011, p. 463-464, ISBN 978-3-642-00823-8
- ↑ The scientist
- ↑ „Institutul pentru chimia plantelor, Halle”. Arhivat din original la . Accesat în .
- ↑ Bruno Cetto: „Der große Pilzführer”, vol. 1, ed. a 5-a, Editura BLV Verlagsgesellschaft, München, Berna, Viena 1979, p. 23-24, ISBN 3-405-12116-7
- ↑ Till E. Lohmeyer & Ute Künkele: „Pilze – bestimmen und sammeln”, Editura Parragon Books Ltd., Bath 2014, p. 8-19, ISBN 978-1-4454-8404-4
Bibliografie
- Hans Joachim Fröhlich (ed.): „Vitalisierung von Bäumen”, Editura Deutsche Stiftung Denkmalschutz, Monumente Publikationen, Bonn, 2005, ISBN 978-3-936942-49-1
- P. Sitte, E. W. Weiler sia altii: „Straßburger Lehrbuch der Botanik”, Editura Spektrum Akademischer Verlag, Heidelberg Berlin 2002, ISBN 3-8274-1010-X
- David D. Douts. jr, Rita Seidel: „The contribution of arbuscular mycorrhizal fungi to the success or failure of agricultural practices”,
Legături externe
 Materiale media legate de Micoriză la Wikimedia Commons
Materiale media legate de Micoriză la Wikimedia Commons